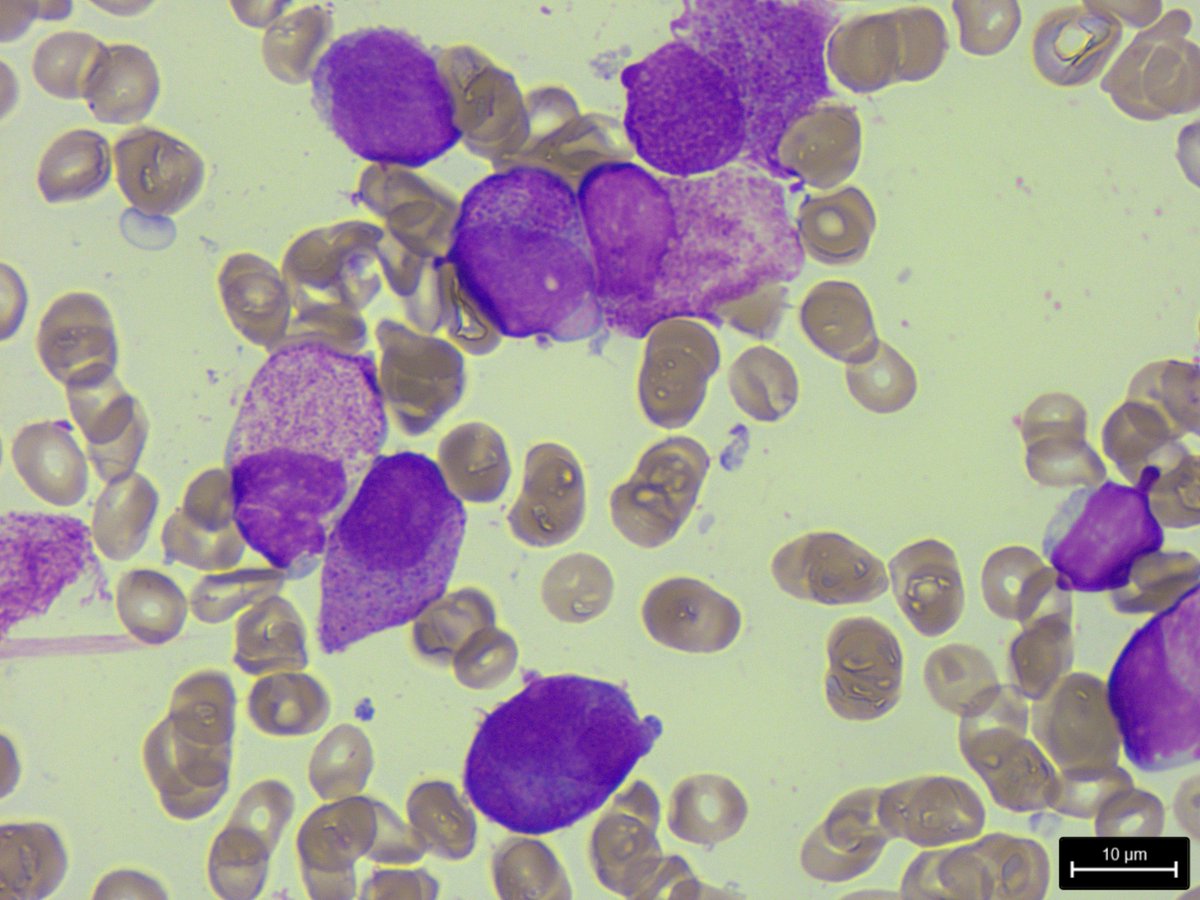
Pour ce remettre en jambe. 
Jeune patiente qui présente depuis 1 semaine :
- Des hématomes spontanés 
- Une asthénie, sans perte de poids
A l'hémogramme, pancytopénie 
Photos de la moelle ci-joint (diag ?)

Canakinumab Le Chat Noir
@canakinumab_
Assistant spécialiste de biologie médicale 🔬
ID: 2182667696
08-11-2013 18:01:45
3,3K Tweet
1,1K Takipçi
1,1K Takip Edilen










Question pour le commu hémato Eric Guiheneuf 🔬 Nicolas Duployez Véronique Saada : Je ne comprends pas le nouveau statut des LAM post thérapeutique et avec anomalies constit. Est ce que c'est une description complémentaire ou est ce que ça arrive avant la classification FAB ?




Le Twitter medical notamment Eric Guiheneuf 🔬 besoin de vous : pour le concours de PH est ce que une année de docteur junior compte comme une année d'assistanat ?